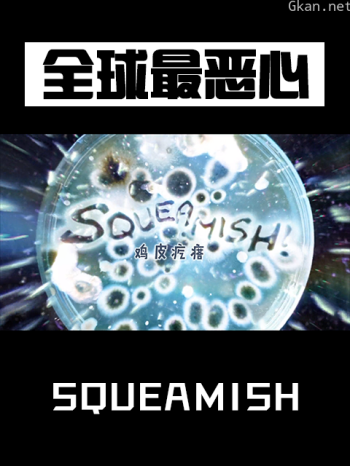
全球最恶心

2011 | 即将上映
豆瓣:8.4分

金梦
2011 | 已完结
豆瓣:8.2分

高清越战
2011 | 已完结
豆瓣:8.9分

大脑游戏 第一季
2011 | 更新至中

夜行追踪
2011 | HD中字
豆瓣:7.4分

蠢蛋搞怪秀3.5
2011 | 已完结
豆瓣:9.3分

荒野求生 第七季
2011 | 全3集
豆瓣:8.6分

帝国的兴衰
2011 | 全12集
豆瓣:9.6分

玄奘之路
2011 | 全6集

回望勾吴
2011 | HD
豆瓣:8.5分

飞行员之眼:上海
2011 | 已完结
豆瓣:9.6分

宇宙的奇迹
2011 | 即将上映
豆瓣:7.4分

噩梦工厂
2011 | 正片
豆瓣:8.3分

俄罗斯——在老虎,熊和火山之间
2011 | 正片
豆瓣:7.8分

五月天追梦
2011 | HD
豆瓣:8.2分

尼姆计划
2011 | 即将上映
豆瓣:9.3分

被误解的女性
2011 | 已完结

西岸酷车厂 第二季
2011 | 已完结

西岸酷车厂 第一季
2011 | HD

传奇人物
2011 | HD

海啸与樱花
2011 | HD
豆瓣:8.3分

不可击败
2011 | 正片
豆瓣:6.5分

本拉登之死
2011 | 已完结
豆瓣:8.5分

全力以赴
2011 | HD中字
豆瓣:7.7分

乔布斯:最后一件事情
2011 | 已完结
豆瓣:9.5分

空中浩劫 第十一季
2011 | HD中字

你所见如我所见吗
2011 | 已完结

恐龙的行军
2011 | HD中字
豆瓣:8.7分

寿司之神
2011 | HD国语
豆瓣:4.8分

火力全开
2011 | 已完结

鹰击长空
2011 | HD
豆瓣:8.0分

他们在岛屿写作:朝向一首诗的完成
2011 | HD

地平线系列:疼痛的秘密
2011 | 完结

黑暗物质
2011 | HD
豆瓣:7.6分

BBC地平线系列:你看到我所见了么
2011 | HD
豆瓣:9.1分

BBC自然世界:沙漠蚂蚁帝国
2011 | 完结
豆瓣:8.5分

女王的宫殿
2011 | HD

冰的秘密
2011 | HD

职业意特女
2011 | 完结

中国古代玉文化
2011 | 完结
豆瓣:8.5分

我们的起源
2011 | 完结
豆瓣:8.5分

书籍之美
2011 | HD
豆瓣:5.5分

国家地理-寻找下一个地球
2011 | 完结

里克·斯坦的西班牙美食之旅
2011 | 完结
豆瓣:8.9分

恐龙行星
2011 | 完结
豆瓣:8.8分

肮脏的城市
2011 | 完结
豆瓣:8.6分

希特勒启示录
2011 | 完结
豆瓣:9.4分
全球最恶心
2011 | 完结
豆瓣:7.8分

可爱的豆助
2011 | 完结
豆瓣:8.6分

满江红:抗战珍稀影像全纪录
2011 | 完结
豆瓣:9.4分

鸟瞰地球
2011 | HD
豆瓣:7.8分

我们能永生吗?
2011 | HD
豆瓣:6.7分

乌贼在一个晚上爱与死亡
2011 | 完结
豆瓣:9.2分

人体奥秘
2011 | HD
豆瓣:5.6分

BBC地平线:一度代表什么?
2011 | 完结
豆瓣:9.3分

万物与虚无
2011 | 完结
豆瓣:8.1分

流行世界的美食
2011 | HD中字
豆瓣:4.3分

星球大战:星球战士
2011 | 完结

頂尖製造
2011 | 完结
豆瓣:7.2分

爱上新玩意
2011 | 完结
豆瓣:7.8分

震惊世界的一天
2011 | 更新至20241206
豆瓣:7.0分

生活真美好
2011 | 已完结
豆瓣:9.2分

意大利花园
2011 | 已完结
豆瓣:9.3分

萌宠成长记 第一季
2011 | 已完结
豆瓣:5.3分

里克·斯坦的蓝调寻味之旅
2011 | 已完结
豆瓣:8.3分

博物馆的秘密 第二季
2011 | HD中字
豆瓣:5.9分

唱你的歌
2011 | HD中字
豆瓣:7.2分

疯马歌舞秀
2011 | HD
豆瓣:4.2分

猫科大战:狮子VS猎豹
2011 | HD
豆瓣:5.8分

BBC 地平线系列:看星
2011 | HD
豆瓣:7.8分

BBC 地平线系列:怀胎九月
2011 | HD
豆瓣:7.8分

地平线系列:你是好的还是坏的
2011 | HD
豆瓣:7.4分

阿SAM



